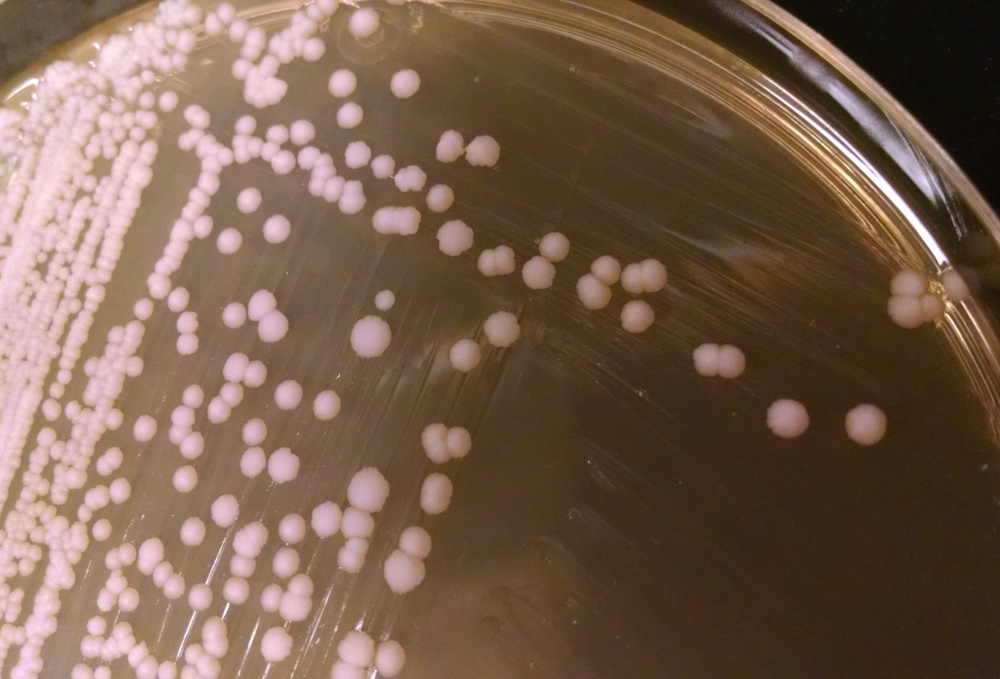
yeast plate

Process
Research isn't just about results — it's also about how you get there. This section offers a look at the practical side of science: the environments, tools, and routines that drive discovery. From code to centrifuges, spreadsheets to sampling sites, process matters.
At the Lab Bench
Precision, repetition, and a good understanding of protocols define the lab environment. Whether it’s preparing libraries, running gels, or pipetting samples, lab work blends technique with routine. It’s hands-on, often high-stakes, and rarely clean for long.








Out in the Field
Some data has to be earned the long way — by stepping outside. Fieldwork can mean early mornings, unpredictable weather, and a bit of logistics, but it brings context to the samples and systems we study. It connects research with place.





_2.JPG)

At a Desk
Much of research happens in front of a screen. Planning experiments, writing code, processing results, drafting papers — it all begins here. Monitors glow, scripts run, and notes stack up. It’s where abstract questions meet data-driven answers.





Getting the Work Out There
Sharing research is a core part of the scientific process — whether it’s at a conference, in front of a poster, or around a table in a meeting room. Presenting helps clarify ideas, invite feedback, and connect with others working in similar spaces. It’s as much about listening and responding as it is about speaking.




Elements of the Work
The objects and systems that show up in research are as varied as the questions being asked. Microscopes, gels, pipettes, spreadsheets, zebrafish, cells, PCR machines, yeast, and the occasional wallaby — they’re all part of it. Some are tools, some are samples, and some are systems under study. Together, they reflect the texture and variety of day-to-day scientific work.